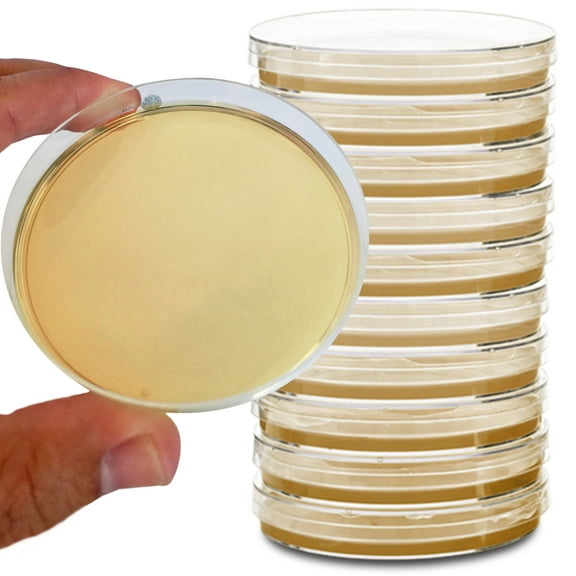
Potato Dextrose Agar Plates - Evviva Sciences - Prepoured Potato Dextrose Agar PDA Petri Dishes - Excellent Growth Medium - Great for Mushrooms & Science Fair Projects

Hero image 0 of Sabouraud Dextrose Agar Plates - Evviva Sciences - Excellent for Cultivating Yeasts, Molds, & Other Fungus - 10 Prepoured SDA Petri Dishes - Great for Science Fair Projects!, 0 of 5
Sabouraud Dextrose Agar Plates - Evviva Sciences - Excellent for Cultivating Yeasts, Molds, & Other Fungus - 10 Prepoured SDA Petri Dishes - Great for Science Fair Projects!
(No ratings yet)
Key item features
- PROFESSIONAL PACKAGING BUT NOT INDIVIDUALLY SEALED: We package all agar plates using biotech methods in bags of 5 plates, but the plates are not individually wrapped with film. They are convenient and ready to use!
- DEFECTS ARE RARE BUT WE WILL REPLACE ANY DAMAGED PLATES IF IT HAPPENS - We are taking extra care to package this product so that you receive 10 high quality SDA plates. Plates should arrive in excellent condition or let us know and we will replace them. We make new plates every day, so if there are any problems we can send newly poured agar your way asap.
- EXCELLENT AGAR CHOICE FOR SCIENCE FAIR AND CLASSROOM PROJECTS: SDA agar can be used for science fair projects or in class experiments because it grows a very wide range of fungus!
- DIY MOLD DETECTION. If you are worried about mold at your home or office, you can take samples and add them to these plates to test for molds. However identifying the types of molds growing is not usually possible without a lab test.
- IN EVVIVA WE TRUST: We are taking extra care to package our plates so that you receive 10 high quality SDA plates. If there are any problems whatsoever with your agar plates, just contact us and we will refund you in full or replace the plates if you prefer.
Specs
- Edu focusBiology
- Science model & kit typeScience Models
- BrandEvviva Sciences
- Pieces1
- Materialagar
- Color typeYellow
Current price is USD$27.99
Price when purchased online
- Free shipping
Free 30-day returns
How do you want your item?
Columbus, 43215
Arrives by Fri, Feb 13
|Sold and shipped by Evviva Sciences, LLC
4.296296296296297 stars out of 5, based on 27 seller reviews(4.3)27 seller reviews
Free 30-day returns
Similar items you might like
Based on what customers bought
Discovery #MINDBLOWN 2-in-1 Reversible Planetarium Space Projector for Children and Elementary School, White $33.90
 $3390current price $33.90
$3390current price $33.90Discovery #MINDBLOWN 2-in-1 Reversible Planetarium Space Projector for Children and Elementary School, White
5594.4 out of 5 Stars. 559 reviewsSave withShipping, arrives tomorrowFan Car, for Science Experiments $27.91
 $2791current price $27.91
$2791current price $27.91Fan Car, for Science Experiments
Shipping, arrives in 3+ daysHEMOTON 100 Pieces Coverslips Biological Science Education Tools Slides for Microscope Kit $18.15
 $1815current price $18.15+$2.99 shipping
$1815current price $18.15+$2.99 shippingHEMOTON 100 Pieces Coverslips Biological Science Education Tools Slides for Microscope Kit
Shipping, arrives in 3+ days12PK Raw Apatite, Mineral Specimens - Approx. 1" - Geologist Selected & Hand Processed - Great for Science Classrooms - Class Pack - Eisco Labs $24.99
 $2499current price $24.99
$2499current price $24.9912PK Raw Apatite, Mineral Specimens - Approx. 1" - Geologist Selected & Hand Processed - Great for Science Classrooms - Class Pack - Eisco Labs
Shipping, arrives in 3+ daysAlmencla DIY Science Experiments Holographic Bioscope Set Stem Teaching Projects DIY Science Toys Model Kits for Supplies Dorm Present $14.99
 $1499current price $14.99
$1499current price $14.99Almencla DIY Science Experiments Holographic Bioscope Set Stem Teaching Projects DIY Science Toys Model Kits for Supplies Dorm Present
Shipping, arrives in 3+ daysNew Organic Chemistry Scientific Molecular Models Teach Set $22.99
 $2299current price $22.99
$2299current price $22.99New Organic Chemistry Scientific Molecular Models Teach Set
Shipping, arrives in 3+ daysClearance Beginner Microscope Kit - 8.7 x 4.7 x 3.1in, 100X-1200X Magnification with LED & Specimen Tools for Science Education(White) $15.99 Was $19.99
Now$1599current price Now $15.99, Was $19.99$19.99Beginner Microscope Kit - 8.7 x 4.7 x 3.1in, 100X-1200X Magnification with LED & Specimen Tools for Science Education(White)
Shipping, arrives in 3+ daysEarly Education Toys & Improved Ferrofluid Display with Two Small for Interactive Learning and Science Experiments $14.75
$1475current price $14.75Options from $14.75 – $15.54Early Education Toys & Improved Ferrofluid Display with Two Small for Interactive Learning and Science Experiments
Shipping, arrives in 3+ daysWEUVEB Electronic Conveyor Belt Stem Kit for Building and Experimenting Science Projects $12.02
 $1202current price $12.02
$1202current price $12.02WEUVEB Electronic Conveyor Belt Stem Kit for Building and Experimenting Science Projects
Shipping, arrives in 3+ daysClearance LKWLPD 10 Pack Magnetic Levitation Experiment Set Educational Floating Model for Classroom Science Physics STEM Learning Teaching Tool $11.69 Was $13.59
Clearance Now$1169current price Now $11.69, Was $13.59$13.59+$3.99 shipping
Now$1169current price Now $11.69, Was $13.59$13.59+$3.99 shippingLKWLPD 10 Pack Magnetic Levitation Experiment Set Educational Floating Model for Classroom Science Physics STEM Learning Teaching Tool
Shipping, arrives in 3+ daysLOLIPPYY 1Set Classroom Geology Kit DIY Earth with Cross Section Layers for Stem Science Projects $10.47
 $1047current price $10.47
$1047current price $10.47LOLIPPYY 1Set Classroom Geology Kit DIY Earth with Cross Section Layers for Stem Science Projects
Shipping, arrives in 3+ daysAir-powered Car STEM Learning Tool Science Experiment Creative Science Building $10.14
 $1014current price $10.14+$0.99 shipping
$1014current price $10.14+$0.99 shippingAir-powered Car STEM Learning Tool Science Experiment Creative Science Building
Shipping, arrives in 3+ days
About this item
Product details
Easy to use pre-poured sabouraud dextrose agar petri dishes (SDA plates) for the detection of yeasts, molds, and other fungus. NO pouring your own plates, which is time consuming. Your plates will arrive in excellent condition or we will replace them no questions asked. This is an excellent science kit to learn microbiology and great for laboratory use. These plates are excellent for mold growth. Each plate is coated with a thick layer of agar perfect for fungal growth! See increased growth compared to other products. The thick agar surface prevents cracking and drying of the plates as seen with other kits. 100% money back guaranteed if you don't absolutely love your set. Kit Contents: 1. 10 pre-poured petri dishes with agar. Here are some basic Instructions: 1. Unopened plates can be refrigerated or stored at room temperature. 2. If refrigerated, take out sabouraud dextrose agar plates (SDA petri dishes) and let them warm up to room temperature for about 30min to 1hr. 3. Add fungal cultures to the plates. 4. Close the lid and turn the plate upside down so that the lid is on the bottom and agar is on the top. 5. Incubate plates at about room temperature in the dark preferably. 6. Fungal colonies should be visible in several days.
- PROFESSIONAL PACKAGING BUT NOT INDIVIDUALLY SEALED: We package all agar plates using biotech methods in bags of 5 plates, but the plates are not individually wrapped with film. They are convenient and ready to use!
- DEFECTS ARE RARE BUT WE WILL REPLACE ANY DAMAGED PLATES IF IT HAPPENS - We are taking extra care to package this product so that you receive 10 high quality SDA plates. Plates should arrive in excellent condition or let us know and we will replace them. We make new plates every day, so if there are any problems we can send newly poured agar your way asap.
- EXCELLENT AGAR CHOICE FOR SCIENCE FAIR AND CLASSROOM PROJECTS: SDA agar can be used for science fair projects or in class experiments because it grows a very wide range of fungus!
- DIY MOLD DETECTION. If you are worried about mold at your home or office, you can take samples and add them to these plates to test for molds. However identifying the types of molds growing is not usually possible without a lab test.
- IN EVVIVA WE TRUST: We are taking extra care to package our plates so that you receive 10 high quality SDA plates. If there are any problems whatsoever with your agar plates, just contact us and we will refund you in full or replace the plates if you prefer.
info:
We aim to show you accurate product information. Manufacturers, suppliers and others provide what you see here, and we have not verified it.
Specifications
Edu focus
Biology
Science model & kit type
Science Models
Items included
10 pre-poured petri dishes with agar
Brand
Evviva Sciences
Warranty
Warranty information
Please be aware that the warranty terms on items offered for sale by third party Marketplace sellers may differ from those displayed in this section (if any). To confirm warranty terms on an item offered for sale by a third party Marketplace seller, please use the 'Contact seller' feature on the third party Marketplace seller's information page and request the item's warranty terms prior to purchase.
Compare with similar items
| Product | Viewing this itemSabouraud Dextrose Agar Plates - Evviva Sciences - Excellent for Cultivating Yeasts, Molds, & Other Fungus - 10 Prepoured SDA Petri Dishes - Great for Science Fair Projects!  $27.99 current price $27.99 | Discovery #MINDBLOWN 2-in-1 Reversible Planetarium Space Projector for Children and Elementary School, White  $33.90 current price $33.905594.4 out of 5 Stars. 559 reviews | Microscope for Beginners - 200X to 1000X with LED, Metal Base, and Specimen Kit for Student Science Discovery  Now $19.99 current price Now $19.99, Was $25.99$25.99 | HEMOTON 100 Pieces Coverslips Biological Science Education Tools Slides for Microscope Kit  $18.15 current price $18.15 | WEUVEB 1Set DIY Fiber Optic Light Science Kit Stem Experiment Project  $23.58 current price $23.58 | Early Education Toys & Improved Ferrofluid Display with Two Small for Interactive Learning and Science Experiments  $14.75 current price $14.75 | Early Education Toys & Improved Ferrofluid Display with Two Small for Interactive Learning and Science Experiments  $14.75 current price $14.75 | Almencla DIY Science Experiments Holographic Bioscope Set Stem Teaching Projects DIY Science Toys Model Kits for Supplies Dorm Present  $14.99 current price $14.99 |
|---|
| Edu focus | BiologySabouraud Dextrose Agar Plates - Evviva Sciences - Excellent for Cultivating Yeasts, Molds, & Other Fungus - 10 Prepoured SDA Petri Dishes - Great for Science Fair Projects! | Solar System & AstronomyDiscovery #MINDBLOWN 2-in-1 Reversible Planetarium Space Projector for Children and Elementary School, White | BiologyMicroscope for Beginners - 200X to 1000X with LED, Metal Base, and Specimen Kit for Student Science Discovery | BiologyHEMOTON 100 Pieces Coverslips Biological Science Education Tools Slides for Microscope Kit | PhysicsWEUVEB 1Set DIY Fiber Optic Light Science Kit Stem Experiment Project | Early DevelopmentEarly Education Toys & Improved Ferrofluid Display with Two Small for Interactive Learning and Science Experiments | Early DevelopmentEarly Education Toys & Improved Ferrofluid Display with Two Small for Interactive Learning and Science Experiments | TechnologyAlmencla DIY Science Experiments Holographic Bioscope Set Stem Teaching Projects DIY Science Toys Model Kits for Supplies Dorm Present |
|---|---|---|---|---|---|---|---|---|
| Science model & kit type | Science ModelsSabouraud Dextrose Agar Plates - Evviva Sciences - Excellent for Cultivating Yeasts, Molds, & Other Fungus - 10 Prepoured SDA Petri Dishes - Great for Science Fair Projects! | Science ModelsDiscovery #MINDBLOWN 2-in-1 Reversible Planetarium Space Projector for Children and Elementary School, White | Science Model KitsMicroscope for Beginners - 200X to 1000X with LED, Metal Base, and Specimen Kit for Student Science Discovery | Science Model KitsHEMOTON 100 Pieces Coverslips Biological Science Education Tools Slides for Microscope Kit | Science Model KitsWEUVEB 1Set DIY Fiber Optic Light Science Kit Stem Experiment Project | Science ModelsEarly Education Toys & Improved Ferrofluid Display with Two Small for Interactive Learning and Science Experiments | Science ModelsEarly Education Toys & Improved Ferrofluid Display with Two Small for Interactive Learning and Science Experiments | Science Model KitsAlmencla DIY Science Experiments Holographic Bioscope Set Stem Teaching Projects DIY Science Toys Model Kits for Supplies Dorm Present |
| Pieces | 1Sabouraud Dextrose Agar Plates - Evviva Sciences - Excellent for Cultivating Yeasts, Molds, & Other Fungus - 10 Prepoured SDA Petri Dishes - Great for Science Fair Projects! | 1Discovery #MINDBLOWN 2-in-1 Reversible Planetarium Space Projector for Children and Elementary School, White | -Microscope for Beginners - 200X to 1000X with LED, Metal Base, and Specimen Kit for Student Science Discovery | 1HEMOTON 100 Pieces Coverslips Biological Science Education Tools Slides for Microscope Kit | -WEUVEB 1Set DIY Fiber Optic Light Science Kit Stem Experiment Project | 1Early Education Toys & Improved Ferrofluid Display with Two Small for Interactive Learning and Science Experiments | 1Early Education Toys & Improved Ferrofluid Display with Two Small for Interactive Learning and Science Experiments | -Almencla DIY Science Experiments Holographic Bioscope Set Stem Teaching Projects DIY Science Toys Model Kits for Supplies Dorm Present |
| Material | agarSabouraud Dextrose Agar Plates - Evviva Sciences - Excellent for Cultivating Yeasts, Molds, & Other Fungus - 10 Prepoured SDA Petri Dishes - Great for Science Fair Projects! | -Discovery #MINDBLOWN 2-in-1 Reversible Planetarium Space Projector for Children and Elementary School, White | PlasticMicroscope for Beginners - 200X to 1000X with LED, Metal Base, and Specimen Kit for Student Science Discovery | GlassHEMOTON 100 Pieces Coverslips Biological Science Education Tools Slides for Microscope Kit | PlasticWEUVEB 1Set DIY Fiber Optic Light Science Kit Stem Experiment Project | GlassEarly Education Toys & Improved Ferrofluid Display with Two Small for Interactive Learning and Science Experiments | GlassEarly Education Toys & Improved Ferrofluid Display with Two Small for Interactive Learning and Science Experiments | WoodAlmencla DIY Science Experiments Holographic Bioscope Set Stem Teaching Projects DIY Science Toys Model Kits for Supplies Dorm Present |
Now hiding additional rows in the Table
Popular items in this category
Best selling items that customers love
YCFUN Kids Experiment Science Kit, Circuit Board Kits with 420 Projects & 35 Circuit Parts, Science Experiments STEM Toy for Kids Age 3-12 $43.47 Was $69.99
 SponsoredNow$4347current price Now $43.47, Was $69.99$69.99
SponsoredNow$4347current price Now $43.47, Was $69.99$69.99YCFUN Kids Experiment Science Kit, Circuit Board Kits with 420 Projects & 35 Circuit Parts, Science Experiments STEM Toy for Kids Age 3-12
344.9 out of 5 Stars. 34 reviewsSave withShipping, arrives tomorrowKlever Kits Crystal Growing Kit - Grow 7 Vibrant, Fast-Forming Crystals with LED Display Base, Educational STEM Toys Science Kits for Kids Ages 8-12 $19.99
 Sponsored$1999current price $19.99
Sponsored$1999current price $19.99Klever Kits Crystal Growing Kit - Grow 7 Vibrant, Fast-Forming Crystals with LED Display Base, Educational STEM Toys Science Kits for Kids Ages 8-12
104.8 out of 5 Stars. 10 reviewsSave withShipping, arrives in 2 daysPotato Dextrose Agar Plates - Evviva Sciences - Prepoured Potato Dextrose Agar PDA Petri Dishes - Excellent Growth Medium - Great for Mushrooms & Science Fair Projects $30.30
$3030current price $30.30
$3030current price $30.30Potato Dextrose Agar Plates - Evviva Sciences - Prepoured Potato Dextrose Agar PDA Petri Dishes - Excellent Growth Medium - Great for Mushrooms & Science Fair Projects
12 out of 5 Stars. 1 reviewsShipping, arrives in 3+ daysMicroscope for Kids - Science Kits 100X-1200X Beginner Kids Microscope with Projection Modes, Science Kits for Kids Age 3-12 $24.99
 $2499current price $24.99
$2499current price $24.99Microscope for Kids - Science Kits 100X-1200X Beginner Kids Microscope with Projection Modes, Science Kits for Kids Age 3-12
484 out of 5 Stars. 48 reviewsSave withShipping, arrives tomorrowSTEM Solar Robot Kit 6-in-1 Educational Science Experiment Set $16.79 Was $19.99
 Now$1679current price Now $16.79, Was $19.99$19.99
Now$1679current price Now $16.79, Was $19.99$19.99STEM Solar Robot Kit 6-in-1 Educational Science Experiment Set
Shipping, arrives in 3+ daysClearance UUSUOO 3-IN-1 Science Kits for Kids Age 8-12,120 Science Experiments for Kids Stem Educational Learning Chemistry Set,Christmas Birthday Gifts for 6 7 8 9 Years Old Boys Girls $22.99 Was $27.99
Clearance 2 optionsAvailable in additional 2 optionsNow$2299current price Now $22.99, Was $27.99$27.99Options from $22.99 – $33.99
2 optionsAvailable in additional 2 optionsNow$2299current price Now $22.99, Was $27.99$27.99Options from $22.99 – $33.99UUSUOO 3-IN-1 Science Kits for Kids Age 8-12,120 Science Experiments for Kids Stem Educational Learning Chemistry Set,Christmas Birthday Gifts for 6 7 8 9 Years Old Boys Girls
54.6 out of 5 Stars. 5 reviewsSave withShipping, arrives tomorrowWeFone Microscope Set, Science Kits for Kids, 200X-1200X Compound Microscope Toy with Mobile Phone Holder $29.99 Was $59.98
 Now$2999current price Now $29.99, Was $59.98$59.98
Now$2999current price Now $29.99, Was $59.98$59.98WeFone Microscope Set, Science Kits for Kids, 200X-1200X Compound Microscope Toy with Mobile Phone Holder
634.2 out of 5 Stars. 63 reviewsSave withShipping, arrives tomorrowFreecat Kids Beginner Microscope STEM Kit,Up to 400x Zoom,Gift for Boys & Girls,STEM & Science Toy, Ages 6 $29.99
 $2999current price $29.99
$2999current price $29.99Freecat Kids Beginner Microscope STEM Kit,Up to 400x Zoom,Gift for Boys & Girls,STEM & Science Toy, Ages 6
304.2 out of 5 Stars. 30 reviewsSave withShipping, arrives in 2 daysKahopy Ant Farm Kit for Kids, Ant Colony Observation Kit, Ant Farms Terrarium Educational & Learning Science Kit Toy for Boys, Girls & Adults(Live Ant Not Included) $31.99
 2 optionsAvailable in additional 2 options$3199current price $31.99Options from $31.99 – $32.99
2 optionsAvailable in additional 2 options$3199current price $31.99Options from $31.99 – $32.99Kahopy Ant Farm Kit for Kids, Ant Colony Observation Kit, Ant Farms Terrarium Educational & Learning Science Kit Toy for Boys, Girls & Adults(Live Ant Not Included)
194.6 out of 5 Stars. 19 reviewsShipping, arrives in 3+ daysBest seller Best Choice Products Kids 4-in-1 Science Project Kit, STEM & STEAM DIY Maze, Water, Spider, Battery Lab Experiments $16.99 Was $39.99
Best seller Now$1699current price Now $16.99, Was $39.99$39.99
Now$1699current price Now $16.99, Was $39.99$39.99Best Choice Products Kids 4-in-1 Science Project Kit, STEM & STEAM DIY Maze, Water, Spider, Battery Lab Experiments
2124.4 out of 5 Stars. 212 reviewsSave withShipping, arrives in 2 daysArtSkills Epic Lab Vet Kit for Kids, Animal Anatomy Science Kit for Kids 8 $19.99
 $1999current price $19.99
$1999current price $19.99ArtSkills Epic Lab Vet Kit for Kids, Animal Anatomy Science Kit for Kids 8
Shipping, arrives in 3+ daysCarson Optigami DIY Cardboard Microscope Digiscoping Kit 50x-400x Power Build-Your-Own Microscope $27.99
 $2799current price $27.99
$2799current price $27.99Carson Optigami DIY Cardboard Microscope Digiscoping Kit 50x-400x Power Build-Your-Own Microscope
Save withShipping, arrives in 2 days10Pcs Nutrient Agar Petri Dishes Science Project Kit, 70mm Pre-Poured Agar Plates, Laboratory Experiment Prepoured Supplies for Students $16.12
 $1612current price $16.12
$1612current price $16.1210Pcs Nutrient Agar Petri Dishes Science Project Kit, 70mm Pre-Poured Agar Plates, Laboratory Experiment Prepoured Supplies for Students
Shipping, arrives in 3+ daysEvviva Sciences Nutrient Agar Petri Dishes Science Project Kit, Pre-Poured Agar Plates for Science Experiments, with Experiment eBook $26.80
 $2680current price $26.80
$2680current price $26.80Evviva Sciences Nutrient Agar Petri Dishes Science Project Kit, Pre-Poured Agar Plates for Science Experiments, with Experiment eBook
Shipping, arrives in 3+ daysFreecat DIY Water Spirit Experiment, Science Kit for Kids Ages 8-12 Years, Squishy Kit Experiment Gift for Kids Ages 8 and up. $15.99
 2 optionsAvailable in additional 2 options$1599current price $15.99
2 optionsAvailable in additional 2 options$1599current price $15.99Freecat DIY Water Spirit Experiment, Science Kit for Kids Ages 8-12 Years, Squishy Kit Experiment Gift for Kids Ages 8 and up.
53.4 out of 5 Stars. 5 reviewsSave withBest seller Best Choice Products Kids 4-in-1 Science Project Kit, STEM & STEAM Robot, Solar System, Soap, Weather Lab Experiments $16.99 Was $39.99
Best seller Now$1699current price Now $16.99, Was $39.99$39.99
Now$1699current price Now $16.99, Was $39.99$39.99Best Choice Products Kids 4-in-1 Science Project Kit, STEM & STEAM Robot, Solar System, Soap, Weather Lab Experiments
1574.2 out of 5 Stars. 157 reviewsSave withShipping, arrives tomorrowHopeRock Science Kit for Kids, 58PCS Toys for Boy 8-11 Years, Physics Science Experiments Circuit Board Kit for Kids, STEM Educational Toys Gift for Kids 5 6 7 8 . $33.99
 $3399current price $33.99
$3399current price $33.99HopeRock Science Kit for Kids, 58PCS Toys for Boy 8-11 Years, Physics Science Experiments Circuit Board Kit for Kids, STEM Educational Toys Gift for Kids 5 6 7 8 .
14 out of 5 Stars. 1 reviewsSave withShipping, arrives tomorrow
Customer ratings & reviews
0 ratings|0 reviews
This item does not have any reviews yet














